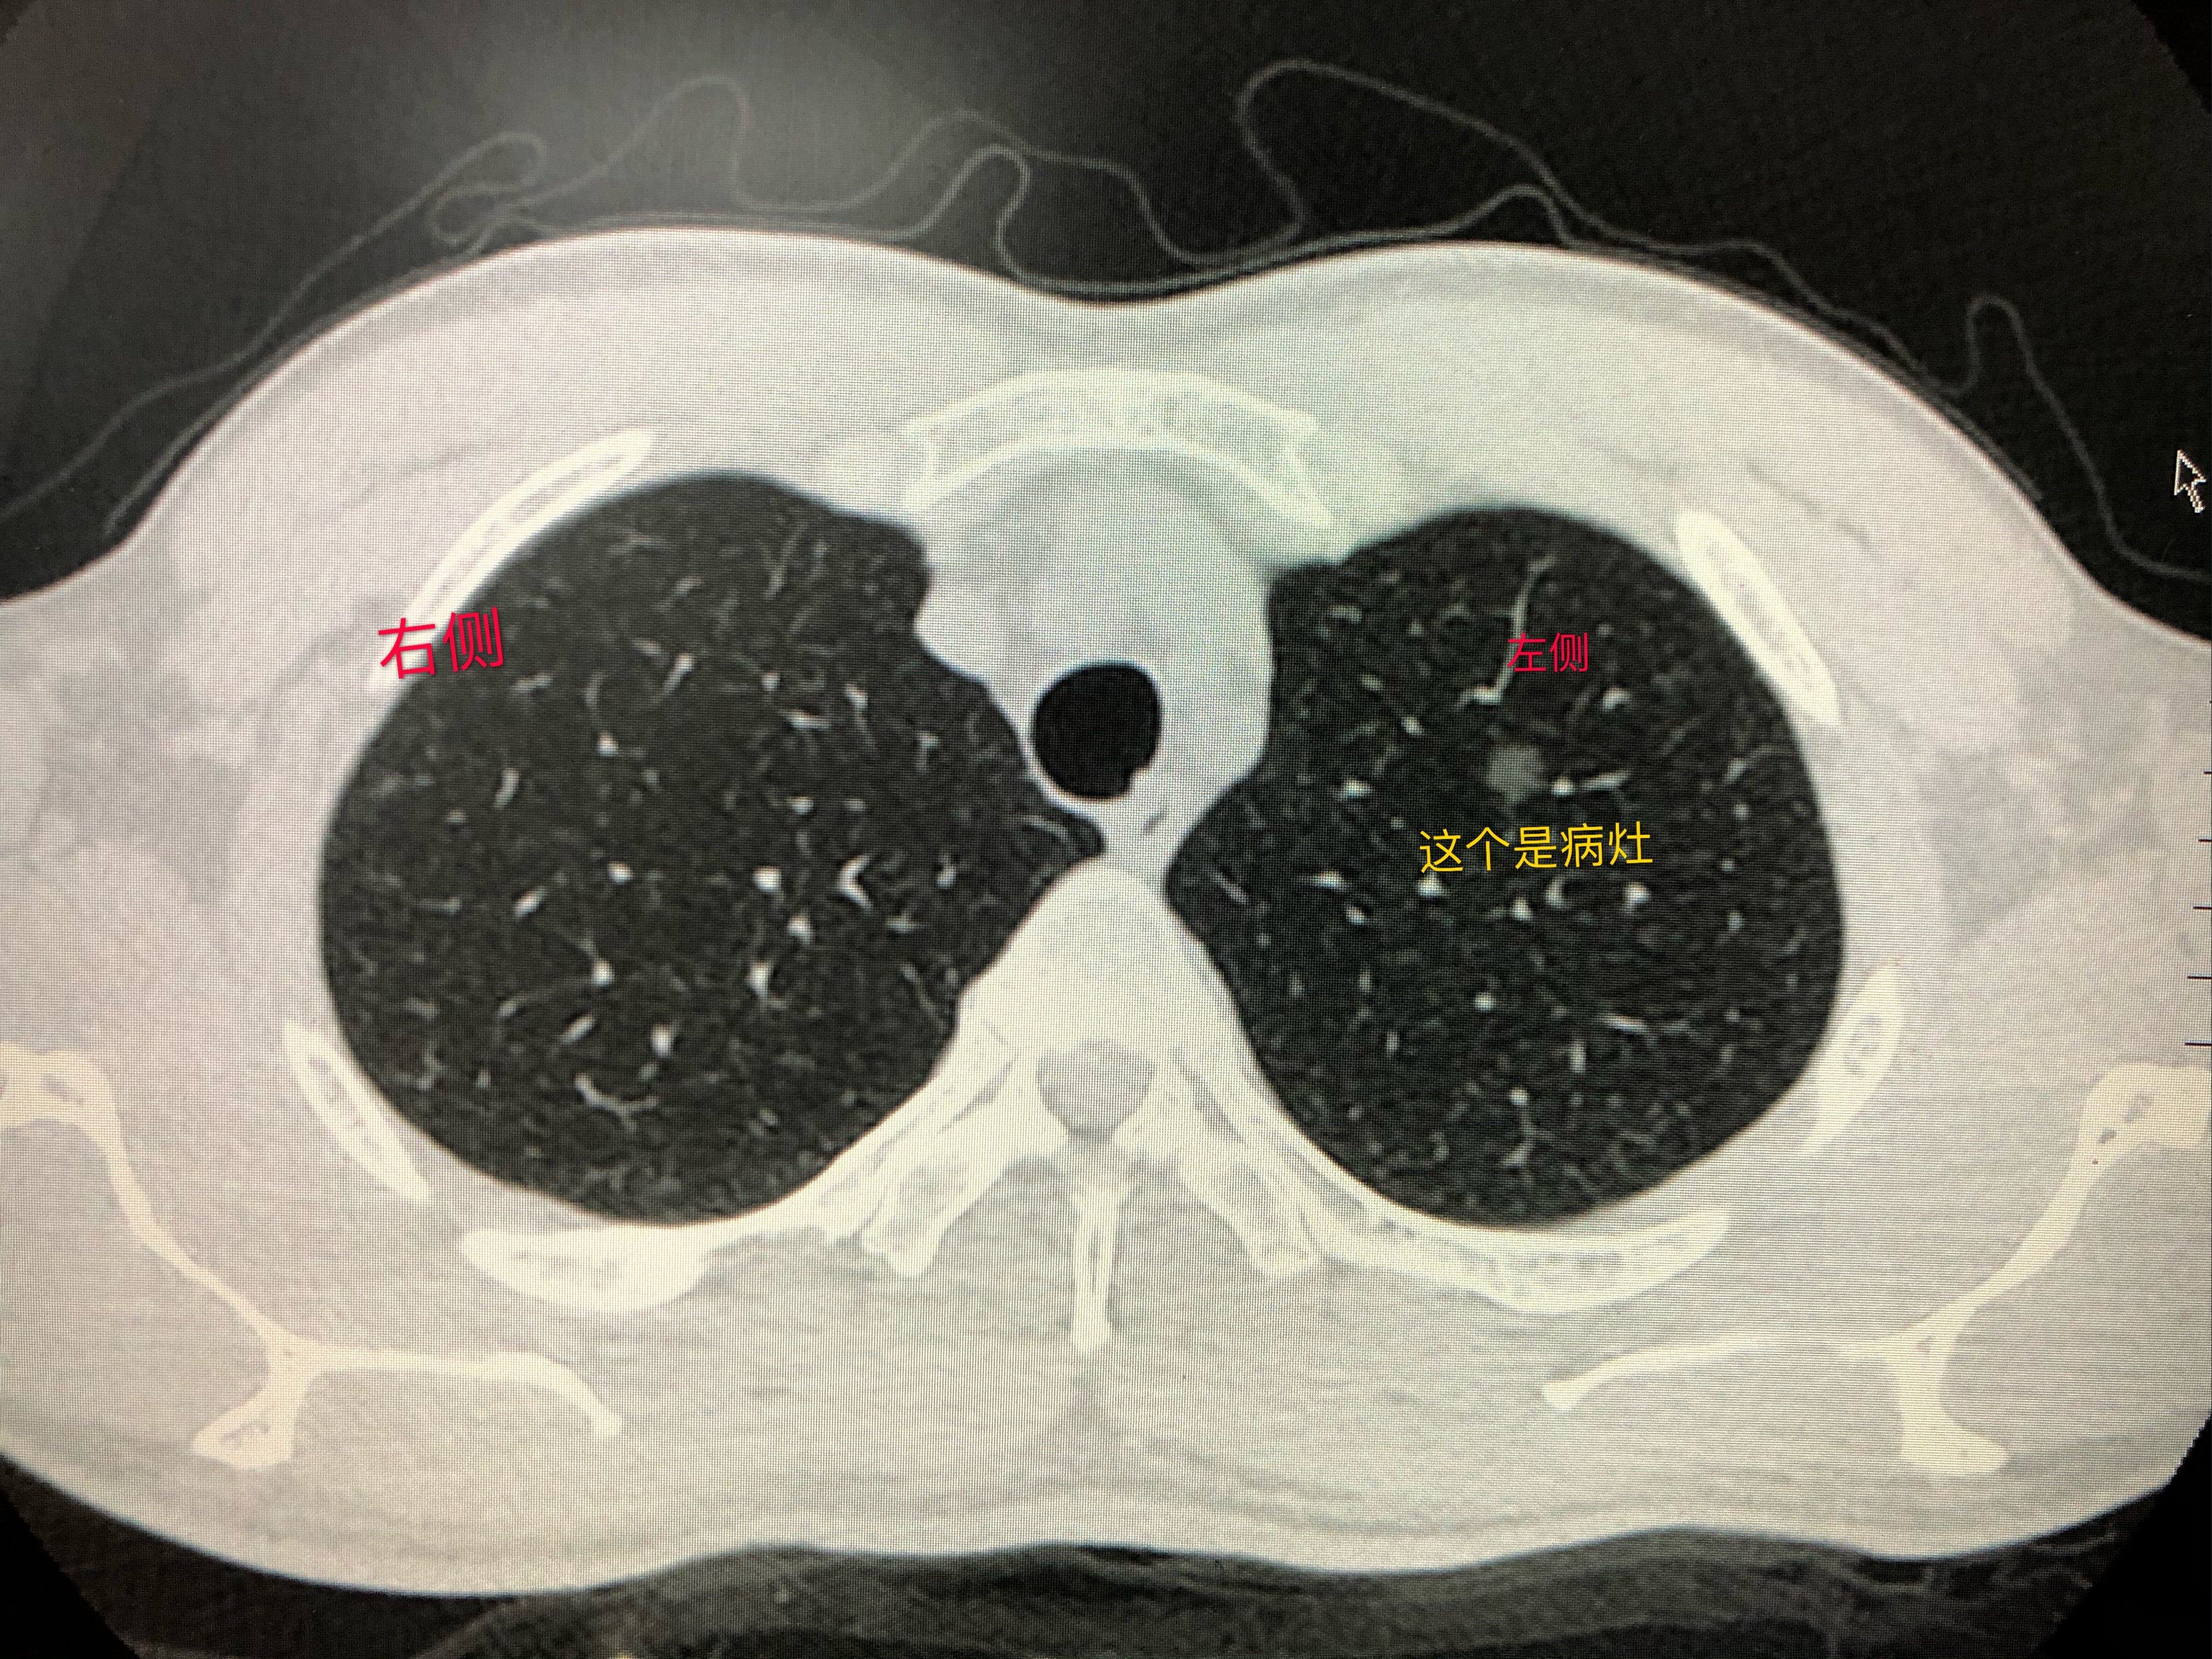
磨玻璃结节 磨玻璃结节

磨玻璃结节并非都是恶性的
肺部的磨玻璃结节是一种影像学的客观表述,因其在胸部CT上表现为云雾状的圆形或不规则病灶,类似半透明玻璃而得名。其实质是肺泡腔充气程度改变,导致局灶性的密度增高,而病变密度还不足以掩盖其中走行的血管和支气管纹理。
随着健康体检中胸部CT检查的普及,被查出肺结节的患者越来越多。而磨玻璃结节因恶变率相对较高,而令众多患者谈“磨”色变,引发过度焦虑与恐慌,进而导致过度治疗。实际上,网传磨玻璃结节可能是肺癌的说法不准确,谈“磨”色变也是不可取的。
肺部磨玻璃结节存在良、恶性之分,其病理基础是肺泡隔增厚,或部分肺泡腔充满液体、细胞、组织碎片。除早期肺癌外,肺部炎症、局灶性间质纤维化、出血或炭末沉积等良性病变亦可表现为磨玻璃结节。
“变坏”的磨玻璃结节,根据其病理和渐进性生长过程,可以分为浸润前阶段(包括不典型腺瘤样增生和原位癌)和浸润阶段(微浸润腺癌和浸润性腺癌)。
参照“分级系统”,初判结节性质
判断肺结节性质的“金标准”是通过手术将结节切除后进行病理学检查。有经验的医生可以通过影像学对肺磨玻璃结节的性质进行初步判断。根据胸部 CT 影像,肺磨玻璃结节可分为无实性成分的纯磨玻璃结节(图3-1)和包含实性成分的混合型磨玻璃结节(图 3-2)。评判肺磨玻璃结节的“好坏”,有客观标准。美国放射学会提出肺结节影像学Lung-RADS分级系统,以下是关于磨玻璃结节的部分:
1 级(阴性,恶性概率 <1%):CT未发现,或确定为良性。
2 级(良性表现或良性生物学行为,恶性概率 <1%):新发混合型磨玻璃结节总直径<6毫米;纯磨玻璃结节直径<30毫米,或≥30毫米且无变化或缓慢生长;3级或4级结节超过3个月无变化。
3 级(可能良性结节,恶性概率为1%~2%):混合型磨玻璃结节总直径≥ 6 毫米,其中实性成分<6毫米,或新发结节总直径<6毫米;纯磨玻璃结节≥ 30毫米或新发。
4A 级(可疑恶性,恶性概率为5%~15%):混合型磨玻璃结节总直径≥ 6 毫米,其中实性成分≥6毫米,但<8毫米;新发或实性成分增长<4毫米。
4B 级(可疑恶性,恶性概率>15%):混合型磨玻璃结节,实性成分≥8毫米,或新发、实性成分增长≥4毫米。
4X 级(可疑恶性,恶性概率 >15%):有额外特征的3级或4级结节,或影像学显示增加恶性倾向的结节。

磨玻璃结节就算是癌,也是一种“懒癌”
磨玻璃结节在20世纪90年代起被发现是肺腺癌的早期表现之一。不过,已有多项研究证实,具有磨玻璃表现的肺癌患者预后较好。在2018年美国临床肿瘤学年会上报道的日本JC0G0804研究结果显示, 在磨玻璃比例超过75%的直径2厘米以下肺癌中,亚肺叶切除后的5 年无复发,生存率高达99.7%。
同时,越来越多的研究也证实,磨玻璃结节发展缓慢,绝大部分纯磨玻璃结节在长达数年的观察期内能保持稳定。在一项包含439个直径≤5毫米的纯磨玻璃结节的研究中,经过5年以上的随访,只有45个(10.3%)结节増大,且只有4个(0.9%)发展成腺癌(2个微浸润腺癌,2个浸润性腺癌),而这4例腺癌病例岀现实性成分的平均时间是3.6年。在另一项包含2392例纯磨玻璃结节(998例直径≥6毫米)的研究中,共确诊73例腺癌,从发现到治疗的平均时间为19个月;其中,22例纯磨玻璃结节发展为部分实性磨玻璃样结节的平均时间是25个月,经过平均78个月的随访, 术后生存率仍为100%。日本的一项包含1046例纯磨玻璃结节的研究中,只有69例(6.6%)在4.3±2.5年的观察中 发展为混合型磨玻璃结节。
由此可见,以磨玻璃结节为表现的肺 腺癌发展缓慢,进展比例低,是一种“懒癌”,患者不需要急于手术治疗。在临床工作中,很大一部分磨玻璃结节经过长时间的随访观察,病灶没有明显进展,且经临床观察及查阅目前的文献,也从未有磨玻璃结节在随访过程中发生快速进展的情况,更不用说发生转移了。